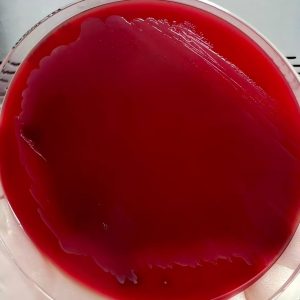

Lactobacillus plantarum,Lp(植物乳杆菌)
植物乳杆菌(Lactobacillus plantarum,Lp)是革兰阳性、兼性厌氧、无芽胞的乳酸杆菌,菌体呈短杆或棒状,两端钝圆,最适生长温度 30–37 ℃,能在 4% NaCl 和 pH 3.2 的苛刻条件下生长,因此胃肠道存活率高,是益生菌制剂的核心菌株之一。
1. 核心生理功能与作用机制 产酸降 pH:快速发酵葡萄糖生成 L-乳酸、乙酸,肠道内 pH 降至 4.5 以下,可抑制大肠杆菌、沙门菌、金黄色葡萄球菌等常见病原菌。 分泌抑菌物质:产生植物乳杆菌素(plantaricin)、环状肽类、H₂O₂ 等广谱抗菌肽,对李斯特菌、艰难梭菌等革兰阳性致病菌具有直接杀灭作用。 屏障强化:上调紧密连接蛋白(ZO-1、occludin)与黏蛋白 MUC2/3 表达,降低肠通透性,减少细菌易位和内毒素入血。 免疫调节:激活树突细胞 TLR2/6 信号,促进 IL-10、TGF-β 分泌,抑制 Th17/Th1 过度炎症;同时增强肠道 sIgA 水平,提高黏膜免疫。 代谢与解毒: – 降解亚硝酸盐、重金属(Cd²⁺)和赭曲霉毒素 A,降低食品和环境毒素暴露; – 分解嘌呤/核苷酸:特定菌株 L. plantarum Q7 可在体外降解尿酸 81.3%,核苷酸 99.97%,通过“肠-肾轴”降低高尿酸血症小鼠的血清尿酸、肌酐和 BUN,并恢复肾小球滤过功能。 抗氧化:自身产生谷胱甘肽过氧化物酶、NADH-氧化酶,降低 DPPH 自由基,提高宿主血浆总抗氧化能力,减轻阿霉素等化疗药物诱导的氧化应激。
2. 临床与实验证据(2020–2025) 肠道疾病: – 急性/抗生素相关性腹泻:Meta 分析(n = 1 922)显示含 Lp 的复合益生菌可缩短腹泻持续时间 25 h,减少复发率 38%; – IBS:随机双盲试验(Lp 299v,4×10¹⁰ CFU/d,4 周)显著改善腹痛、腹胀评分,提高生活质量。 代谢综合征: – Lp K21 在高脂饮食小鼠中抑制脂肪生成,降低血浆总胆固醇 22%,减少肝脂肪变性; – 与铬酵母联合使用可改善 2 型糖尿病患者的空腹血糖(-0.9 mmol/L)和 HOMA-IR。 高尿酸血症:Lp Q7 口服 8 周,模型小鼠血尿酸下降 47%,肠道菌群 B/F 比值恢复至正常,肾脏病理损伤显著减轻。 神经行为:老年大鼠长期喂食 Lp KY1032 + L. curvatus HY7601 混合物,8 周后 Morris 水迷宫潜伏期缩短 28%,海马 BDNF 表达回升,提示改善年龄相关认知减退。
3. 制剂与稳定性 冻干合生元:以脱脂奶粉为基质,加入菊粉(10–20%)或阿拉伯胶(10%)作为益生元,-55 ℃ 冻干后 4 ℃ 储存 90 d,Lp 活菌数仍可维持 8–9 log CFU/g;室温储存则下降 2–3 log,提示冷链运输的重要性。 微胶囊化:采用海藻酸钠-壳聚糖或脂质体包埋,可提高胃酸(pH 2.0,2 h)存活率由 5% 增至 60% 以上,并延缓胆汁盐渗透。 药物相互作用:与抗生素同服可降低活菌数 ≥3 log,建议间隔 2–3 h;对甲硝唑、万古霉素天然耐药,但对克林霉素、四环素敏感,需关注耐药基因横向转移风险。
4. 安全性 Lp 为“公认安全”(GRAS)菌株,全球 30 余年使用史中罕见严重不良反应。免疫功能正常者每日摄入 10⁹–10¹¹ CFU 未见菌血症;对严重免疫抑制、中心静脉置管或短肠综合征患者,应权衡潜在易位风险。
5. 小结与临床提示 植物乳杆菌兼具“产酸-抑菌-屏障-免疫-代谢”多重作用,对腹泻、IBS、代谢综合征、高尿酸血症及老年认知减退均显示辅助疗效。处方时建议: 选择含菌量≥10¹⁰ CFU/袋且有菌株编号(如 Lp 299v、Q7、K21)的冻干制剂; 与益生元(菊粉、低聚果糖)同服可提高定植率; 与抗生素错时 2–3 h,疗程 ≥4 周以获得持久定殖; 对高尿酸或痛风患者,可优先选择已验证“嘌呤降解”功能的 Lp Q7 型产品,配合低嘌呤饮食和足量饮水,监测血尿酸与肾功能。

Fusobacterium nucleatum,Fn(具核梭杆菌)
具核梭杆菌(Fusobacterium nucleatum,Fn)是一种专性厌氧、革兰阴性梭形杆菌,两端尖锐、中间膨胀,呈典型的“纺锤形”或“梭形”,长 5–10 µm,无芽胞、无鞭毛,在血平板上形成灰白色、边缘不规则、β-溶血的斑点状小菌落,常呈“面包屑”样粘附

Aggregatibacter actinomycetemcomitans(伴放线放线杆菌 )
伴放线放线杆菌(Aggregatibacter actinomycetemcomitans,简称 Aa)是一种革兰阴性、无芽胞、无动力的球杆菌,大小约 0.4–0.5 µm × 1.0–1.5 µm,常成对或短链排列,在液体培养基中易形成颗粒状粘壁菌团[^1,2^]。菌落呈“星形”或“星形阴性”两种表型:前者表面粗糙、边缘不规则,中央可见放射状结构;后者则光滑、不粘附[^2,4^]。该菌为兼性厌氧菌,5% CO₂ 微需氧环境生长最佳,在巧克力琼脂上 48 h 可形成直径 ≤2 mm、紧贴培养基表面的灰白色小菌落[^1,2^]。

Curvularia lunata(新月弯孢霉)
新月弯孢霉(Curvularia lunata)
隶属于半知菌亚门(Deuteromycotina)、丝孢纲(Hyphomycetes)、暗色孢菌科(Dematiaceae),是一种常见的暗色丝状真菌。该菌广泛分布于土壤、植物残体及空气中,属于典型的条件致病菌,既可侵染植物,也能引起人类和动物的机会性感染。
在人工培养基上(如PDA)生长迅速,菌落初呈灰褐至深褐色,绒毛状或丝绒状,背面常呈黑色。显微镜下可见分生孢子梗单生或成束,从菌丝侧生,颜色深褐,顶端产生分生孢子。分生孢子深褐色,具3个横隔,通常由4个细胞组成,中间细胞体积明显膨大,颜色较深,使孢子整体呈弯曲或“新月形”外观,是本菌的典型特征。
Curvularia lunata 具有较强的环境适应性,可在温暖潮湿条件下迅速繁殖。它是多种植物(如玉米、水稻、草类植物)的病原真菌之一,能引起叶斑病、穗腐病等。同时,该菌在免疫力低下人群中偶可导致角膜炎、鼻窦炎或肺部感染等机会性感染,因此在临床真菌学中也具有一定的关注价值。






